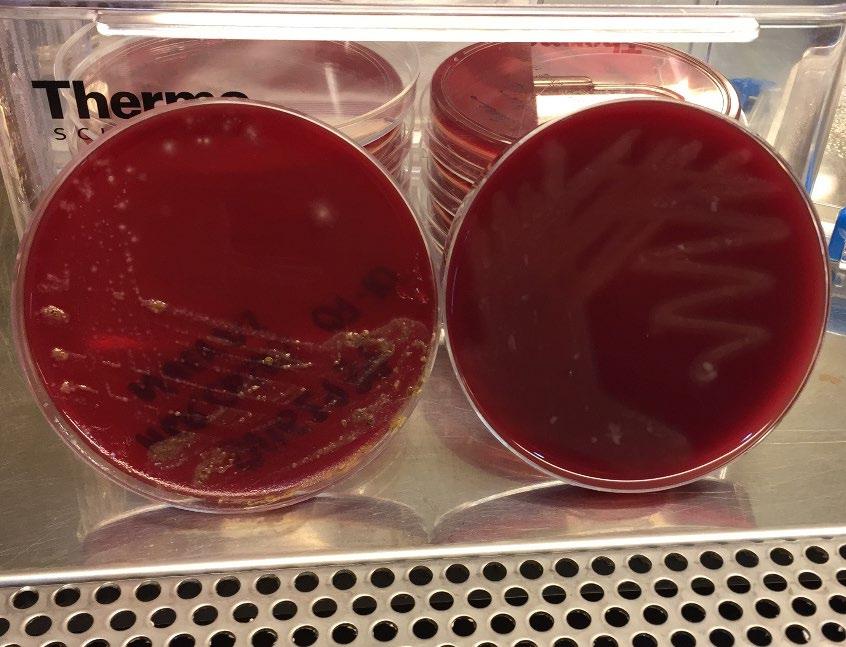
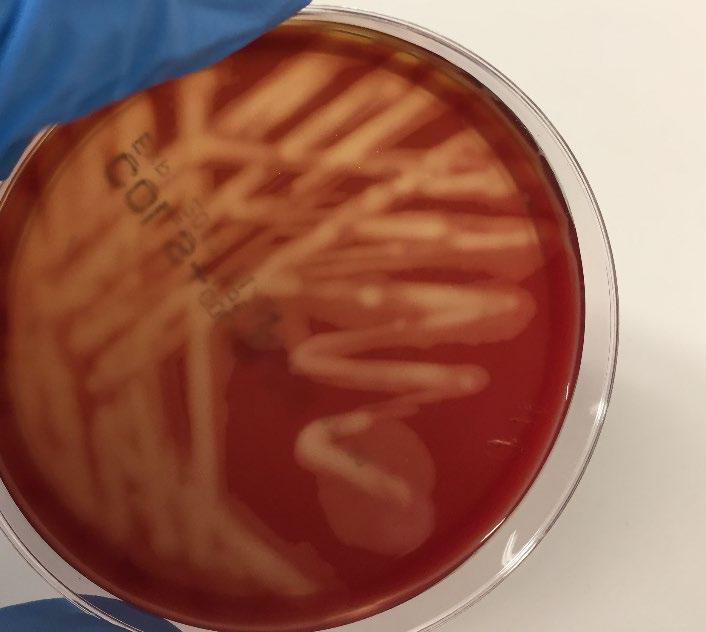

DISENTERIA PORCINA
Ayer, hoy, mañana, y……?.






zootecnia@zootecniaacv.com www.grupozootecnia.es - Licenciado en Veterinaria en la Universidad de Extremadura



Ayer, hoy, mañana, y……?.






zootecnia@zootecniaacv.com www.grupozootecnia.es - Licenciado en Veterinaria en la Universidad de Extremadura




Otras especies:
Brachyspira pilosicoli, murdochii, intermedia, B. innocens, B. hampsoni, B. suanatina, …..

La disentería porcina (DP) es una importante enfermedad infecciosa del cerdo que cursa, en esta especie, con una colitis mucohemorrágica. Aunque puede afectar a animales de cualquier edad, la mayoría de los casos ocurren en animales en la fase de cebo y en las granjas afectadas se producen importantes pérdidas económicas derivadas del incremento del índice de conversión, retrasos en el crecimiento y desigualdad, aumento en los costes de medicación e incremento en las tasas de mortalidad. Se trata de una de las enfermedades digestivas más importantes en la industria porcina y que está presente en todos los países del mundo con producciones importantes de carne de cerdo.















Procesos








Salmonella spp.
Formas digestivas: S. typhimurium
95%
Etiología:
Lawsonia intracellularis
Brachyspira hyodisenteriae
pilosicoli, intermedia, murdochii

Presentación
Individual
Presentación
Complejo 28%













Contacto entre animales + Portadores bacterianos = Transmisión directa

ANIMALES AFECTADOS:
-Transición cebo.
-Reproductores.
-Posdestete.
-Lactación.
TEMPORALIDAD:
Como siempre típico en transición y cebo, se ha incrementado en reproductoras, “menos habitual” encontrar casos clínicos en periodo postdestete y raro en lactación.
FORMAS DE PRESENTACIÓN:
Típica presentación de diarreas muco-hemorrágicas con formas subagudas, pero cuidado crónicas, subclínicas, ….



























Tipo de Muestras: -Heces. -Hisopos rectales. -Paquete intestinal: Intestino Grueso.
Condiciones de las Muestras: -Tiempo. -Temperatura. -Tratamientos.

BIOLOGIA MOLECULAR: qPCR
MICROBIOLOGIA: AISLAMIENTO + MIC´s
OPCIÓN CLÁSICA:
Aislamiento: -Positivo Identificación qPCR MIC´s, MLVA.
-Negativo. (????)
OPCIÓN 2: ZOOTECNIA
qPCR muestra: -Positivo Aislamiento Positivo MIC´s, MLVA.
Negativo.
-Negativo.
Reducción tiempo de diagnóstico
Evitar falsos Negativos

TORSIONES, SINDROME INTESTINO HEMORRÁGICO, ….
Clostridium??????


HEMORRÁGICA






